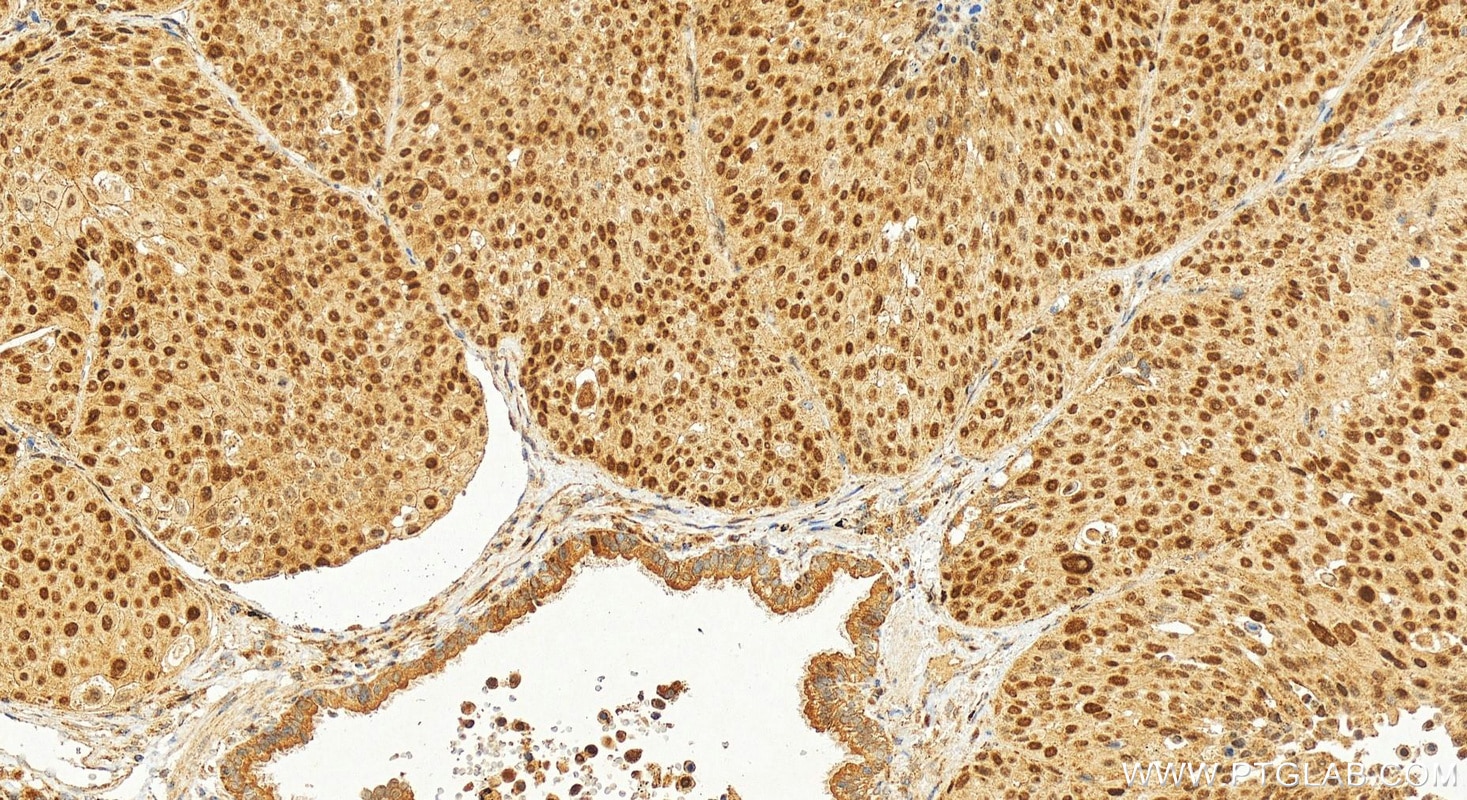
Immunohistochemistry (IHC) staining of human lung squamous cell carcinoma tissue using EZH2 Polyclonal antibody (21800-1-AP)

Tested Applications
| Positive WB detected in | DU 145 cells, A431 cells, HEK-293 cells, HepG2 cells, Jurkat cells, mouse kidney tissue, NIH/3T3 cells, Raji cells, rat kidney tissue, C6 cells |
| Positive IP detected in | HepG2 cells |
| Positive IHC detected in | mouse testis tissue, human lung squamous cell carcinoma tissue, mouse ovary tissue, rat testis tissue Note: suggested antigen retrieval with TE buffer pH 9.0; (*) Alternatively, antigen retrieval may be performed with citrate buffer pH 6.0 |
| Positive IF/ICC detected in | HepG2 cells |
| Positive FC (Intra) detected in | HepG2 cells |
This antibody is not recommended for use in IHC.
Recommended dilution
| Application | Dilution |
|---|---|
| Western Blot (WB) | WB : 1:5000-1:50000 |
| Immunoprecipitation (IP) | IP : 0.5-4.0 ug for 1.0-3.0 mg of total protein lysate |
| Immunohistochemistry (IHC) | IHC : 1:1000-1:4000 |
| Immunofluorescence (IF)/ICC | IF/ICC : 1:400-1:1600 |
| Flow Cytometry (FC) (INTRA) | FC (INTRA) : 0.40 ug per 10^6 cells in a 100 µl suspension |
| It is recommended that this reagent should be titrated in each testing system to obtain optimal results. | |
| Sample-dependent, Check data in validation data gallery. | |
Product Information
21800-1-AP targets EZH2 in WB, IF/ICC, FC (Intra), IP, CoIP, ChIP, RIP, ELISA applications and shows reactivity with human, mouse, rat samples.
| Tested Reactivity | human, mouse, rat |
| Cited Reactivity | human, mouse, rat, pig, sheep |
| Host / Isotype | Rabbit / IgG |
| Class | Polyclonal |
| Type | Antibody |
| Immunogen |
CatNo: Ag16789 Product name: Recombinant human EZH2 protein Source: e coli.-derived, PGEX-4T Tag: GST Domain: 158-261 aa of BC010858 Sequence: HGDRECGFINDEIFVELVNALGQYNDDDDDDDGDDPEEREEKQKDLEDHRDDKESRPPRKFPSDKIFEAISSMFPDKGTAEELKEKYKELTEQQLPGALPPECT Predict reactive species |
| Full Name | enhancer of zeste homolog 2 (Drosophila) |
| Calculated Molecular Weight | 751 aa, 86 kDa |
| Observed Molecular Weight | 90-102 kDa |
| GenBank Accession Number | BC010858 |
| Gene Symbol | EZH2 |
| Gene ID (NCBI) | 2146 |
| RRID | AB_10858790 |
| Conjugate | Unconjugated |
| Form | Liquid |
| Purification Method | Antigen affinity purification |
| UNIPROT ID | Q15910 |
| Storage Buffer | PBS with 0.02% sodium azide and 50% glycerol, pH 7.3. |
| Storage Conditions | Store at -20°C. Stable for one year after shipment. Aliquoting is unnecessary for -20oC storage. 20ul sizes contain 0.1% BSA. |
Background Information
EZH2 (enhancer of zeste homologue 2, also known as KMT6) is a member of Polycomb group (PcG) family and encodes a histone methyl transferase that has an essential role in promoting histone H3 lysine 27 trimethylation (H3K27me3) and epigenetic gene silencing. EZH2 is important for cell proliferation and inhibition of cell differentiation, and is implicated in cancer progression. Overexpression of EZH2 is a marker of advanced and metastatic disease in many solid tumors, including prostate and breast cancer. This antibody detected EZH2 protein as a single band with a molecular weight (MW) of 91-100 kDa in multiple cell lines. The phosphorylation may result in the higher molecular weight (calculated MW as 80-86 kDa). (20935635, 21367748)
Protocols
| Product Specific Protocols | |
|---|---|
| FC protocol for EZH2 antibody 21800-1-AP | Download protocol |
| IF protocol for EZH2 antibody 21800-1-AP | Download protocol |
| IHC protocol for EZH2 antibody 21800-1-AP | Download protocol |
| IP protocol for EZH2 antibody 21800-1-AP | Download protocol |
| WB protocol for EZH2 antibody 21800-1-AP | Download protocol |
| Standard Protocols | |
|---|---|
| Click here to view our Standard Protocols |
Publications
| Species | Application | Title |
|---|---|---|
Mol Cancer Cell surface CD55 traffics to the nucleus leading to cisplatin resistance and stemness by inducing PRC2 and H3K27 trimethylation on chromatin in ovarian cancer | ||
Nat Struct Mol Biol lnc-β-Catm elicits EZH2-dependent β-catenin stabilization and sustains liver CSC self-renewal. | ||
Cancer Res HBXIP and LSD1 Scaffolded by lncRNA Hotair Mediate Transcriptional Activation by c-Myc. | ||
Theranostics Histone H3K27 methyltransferase EZH2 regulates apoptotic and inflammatory responses in sepsis-induced AKI
| ||
Nat Commun CDYL suppresses epileptogenesis in mice through repression of axonal Nav1.6 sodium channel expression.
|
Reviews
The reviews below have been submitted by verified Proteintech customers who received an incentive for providing their feedback.
FH Nikhil (Verified Customer) (10-16-2019) | very nice
 |